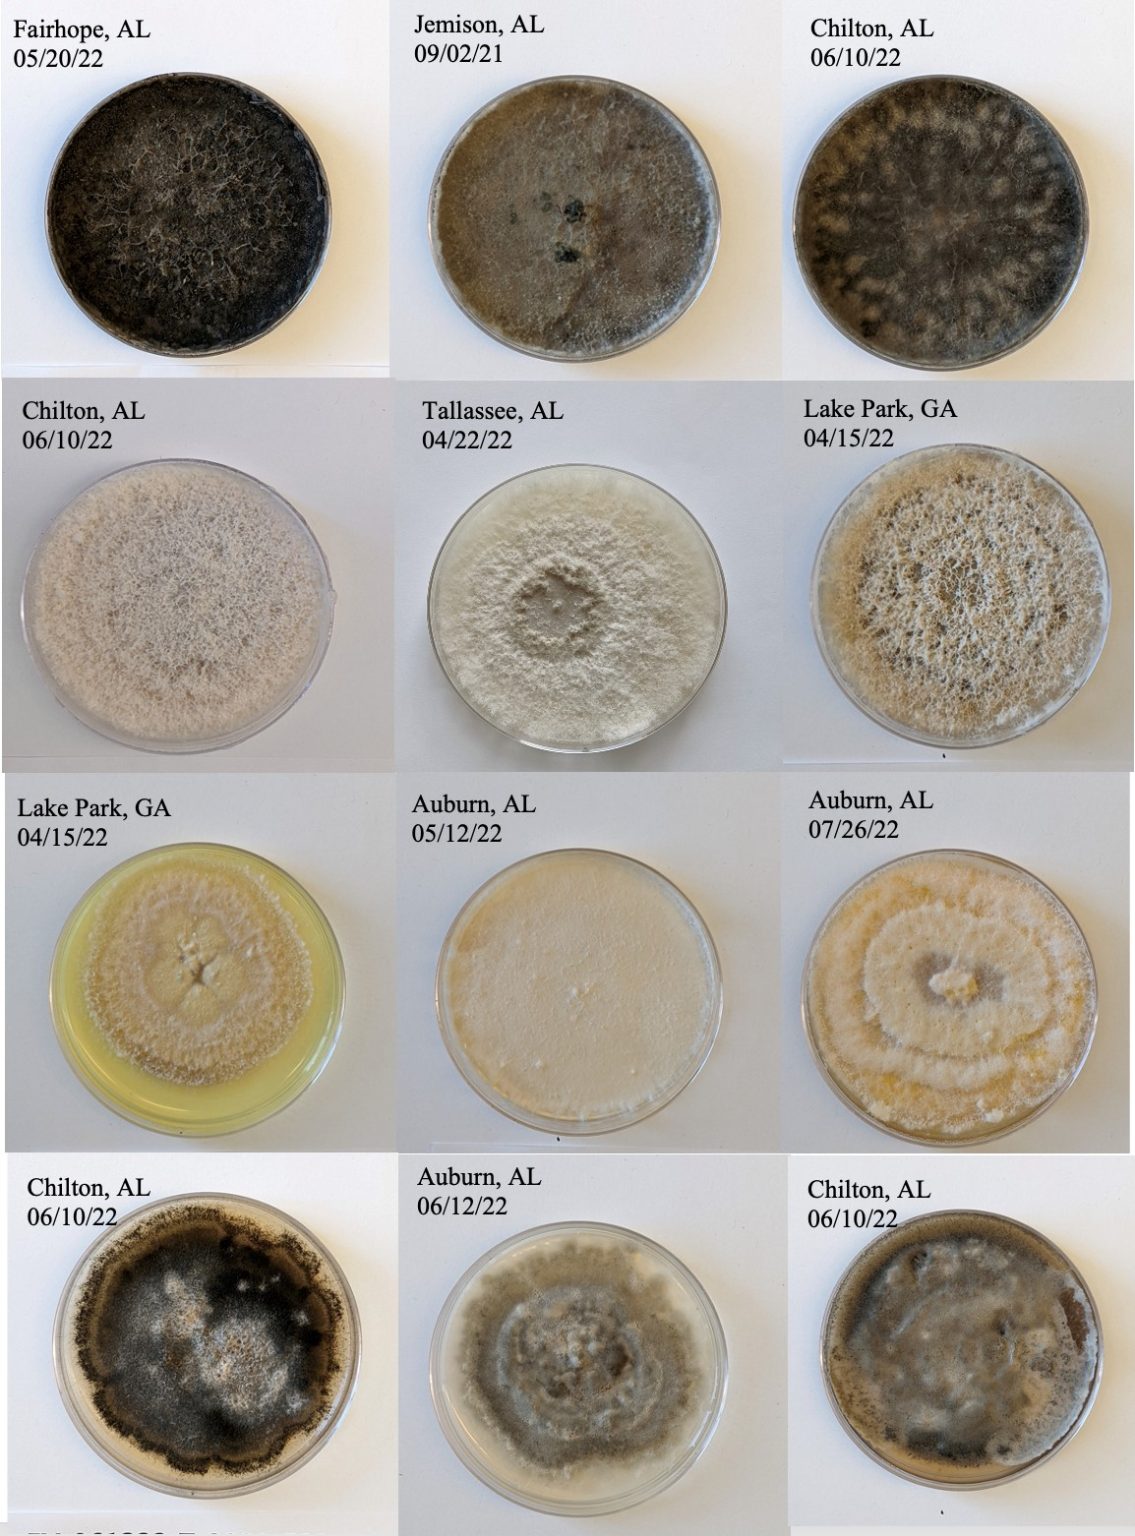
Image 19

The ingraham angle, 7p et @foxnews.
The clerk of the circuit court and county comptroller is characterized as one whose duties are not purely ministerial, but rather an integral part of the entire county governmental process.
Welcome to the tarrantcountycourt.
— the netflix documentary series unlocked:
Miller rivers caulder funeral home provides complete funeral services in chesterfield, sc.
Louise school uses a student management system called skyward.
© 2026 Thesill News. All rights reserved.